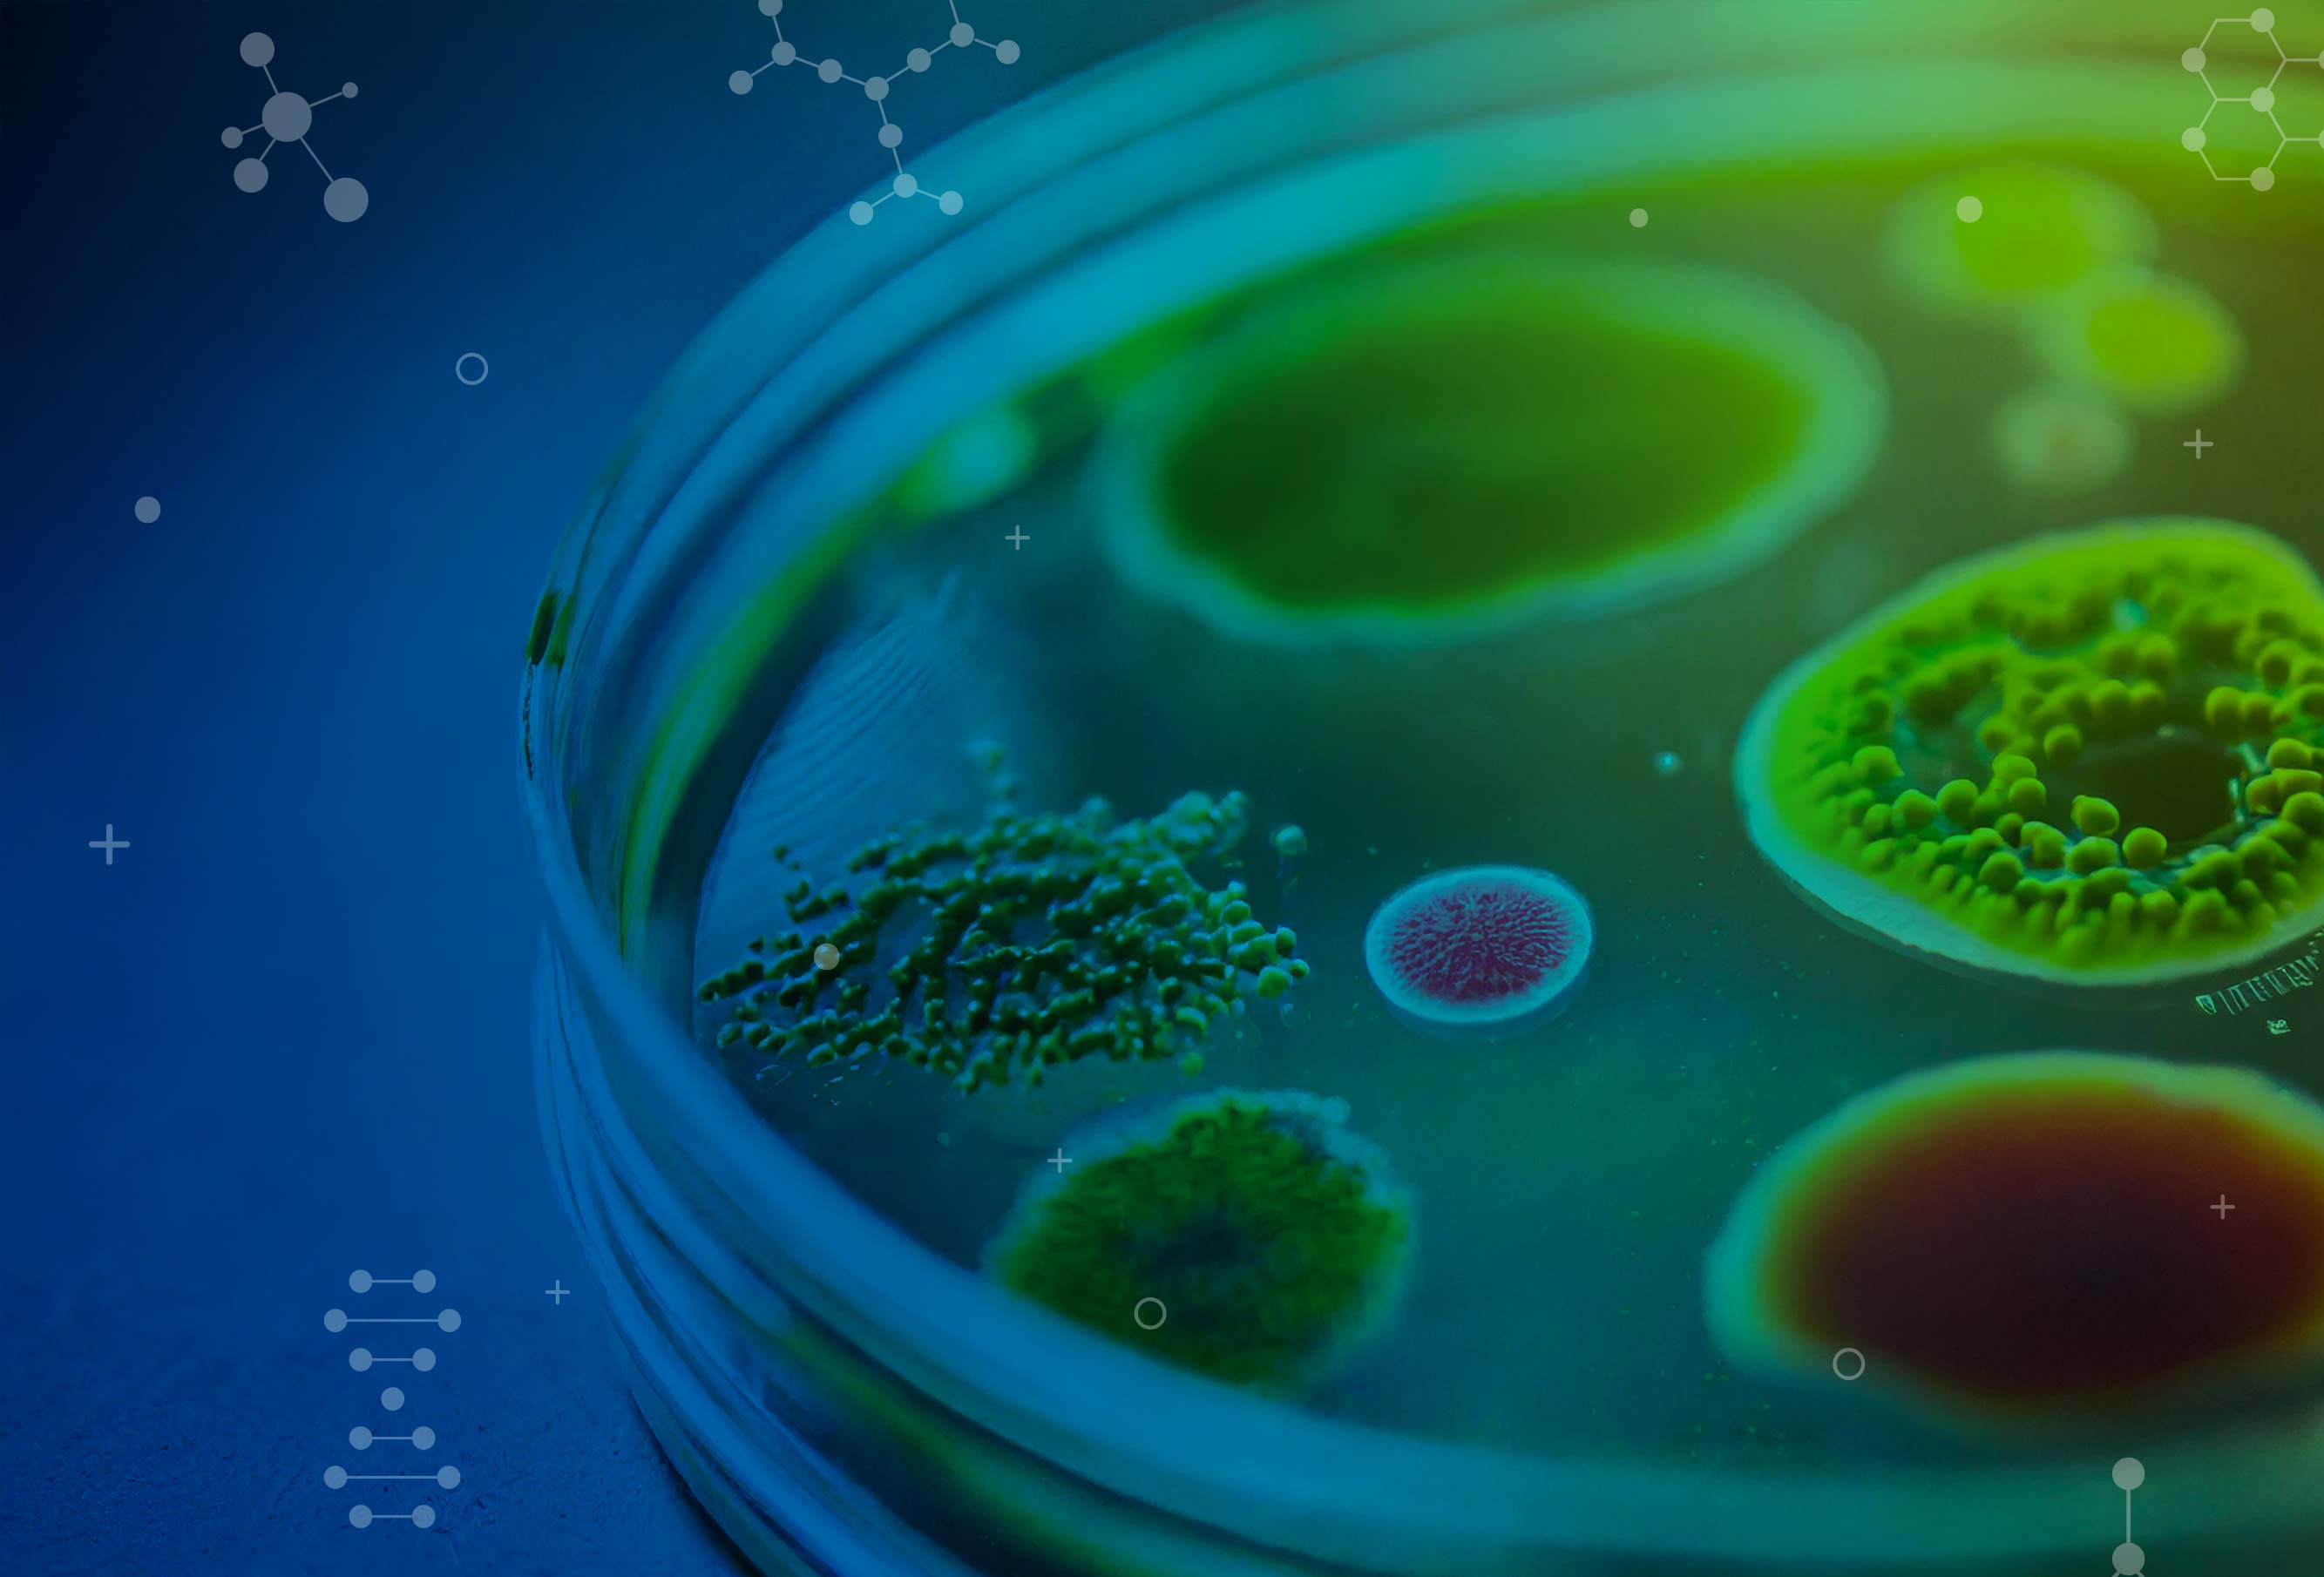

Bienvenidos a COMPAC 2026
El XIX Congreso de Microbiología, Parasitología y Patología Clínica, COMPAC 2026,se consolida como un espacio científico de referencia para el intercambio de conocimientos, experiencias y avances que impactan directamente la salud pública, el diagnóstico clínico y el desarrollo biotecnológico. Este importante encuentro se llevará a cabo los días 8 al 10 de octubre de 2026, en el Centro de Convenciones de Costa Rica, reuniendo a profesionales, investigadores, académicos, estudiantes y representantes de la industria, tanto a nivel nacional como internacional.
La Propuesta 2026 del congreso se estructura en cuatro grandes bloques temáticos que responden a los desafíos actuales y futuros del sector:
Microbiología
incluyendo bacteriología, micología, virología, parasitología, epidemiología de las enfermedades y enfermedades emergentes
Biotecnología e Industria
con énfasis en dispositivos, industria, alimentos y aguas, así como gestión de la calidad
Análisis
Clínicos
Incluye hematología, química clínica, banco de sangre e inmunohematología, toxicología e inmunología
Genética y Biología Molecular
que contempla reproducción, cáncer, paternidad, bioinformática y genómica
El congreso invita a la comunidad científica y profesional a participar activamente mediante la inscripción al evento, la postulación de ponencias y trabajos científicos, así como a las empresas e instituciones interesadas en sumarse como patrocinadores, contribuyendo al fortalecimiento del conocimiento, la innovación y la colaboración interdisciplinaria.
El XIX Congreso de Microbiología, Parasitología y Patología Clínica, COMPAC 2026 es organizado de manera conjunta por el Colegio de Microbiólogos y Químicos Clínicos de Costa Rica, la Facultad de Microbiología de la Universidad de Costa Rica (UCR), la Asociación Costarricense de Microbiología y Parasitología y la Asociación Costarricense de Hematología, reafirmando su compromiso con la excelencia académica y el avance de las ciencias de la salud en el país y la región.
Los esperamos del 8 al 10 de octubre de 2026, en el Centro de Convenciones de Costa Rica, en COMPAC 2026.
Un paraíso tropical
La variedad de paisaje y microclimas que se pueden disfrutar en un mismo día, hacen de este país un destino paradisíaco
00
Días
00
Horas
00
Minutos
00
Segundos













